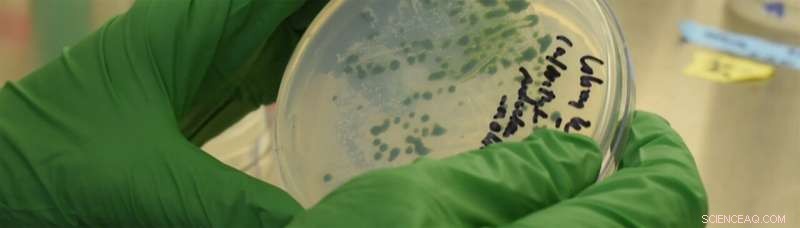
Algae Research: Unlocking Biofuel Potential Through Oxygen Tolerance

A new study from the MSU-DOE Plant Research Laboratory shows how some algae can protect themselves when the oxygen they produce impairs their photosynthetic activity. Researchers in the David Kramer lab started by testing strains (varieties of the same species) for differences in their ability to grow at high oxygen. The researchers then studied both the parents and the offspring to see why they reacted so differently to hyperoxia. The findings from this study give researchers a fuller understanding of not only algal cell biology, but also photosynthesis. Credit: Kara Headley, MSU-DOE Plant Research Laboratory
A new study from the Michigan State University-Department of Energy (DOE) Plant Research Laboratory (PRL) shows how some algae can protect themselves when the oxygen they produce impairs their photosynthetic activity. The discovery also answers a long-standing question about how algae survive when CO2 levels are low.
The findings of this research from the David Kramer lab was recently published in eLife.
In photosynthesis, plants and algae use solar energy to take carbon dioxide (CO2) from the air and synthesize sugars. This process produces oxygen as a byproduct, which earth's animals depend on to breathe. However, oxygen impairs the activity of key photosynthetic reactions. When algae are grown in dense ponds for bioenergy production, this becomes an obstacle.
Algae are used as a crop for biofuels, a renewable energy resource. Growing algae for biofuel production can be sped up by fertilizing the cultures with CO2. However, when algal growth is increased, oxygen output from photosynthesis increases as well, which leads to an accumulation of oxygen in the culture. This exposure to excess oxygen is called hyperoxia.
"The overall goal was to understand how algae respond to hyperoxia, as a first step to making bioenergy strains that are more tolerant to such stresses and thus more productive," said Peter Neofotis, a postdoctoral researcher in the Kramer lab and first author of the paper.
What the researchers found not only shows how algae survive and ways to potentially make more efficient bioenergy crops, but it also answers a decades-long debate in relation to the induction of the Carbon Concentrating Mechanism (CCM) in algal cells.
Differing reactions for differing strains
The researchers started by testing strains (varieties of the same species) for differences in their ability to grow at high oxygen. One called CC-1009 was able to grow steadily in these conditions while another, CC-2343, grew slowly and eventually died. When these two strains were mated, they produced offspring that usually behaved like one parent or the other, but sometimes their behavior was more extreme.
The researchers then studied both the parents and the offspring to see why they reacted so differently to hyperoxia. What they found surprised them because it involved a special process in algae needed for growth at low CO2 but was never previously associated with high oxygen.
Algae cells respond to low CO2 by activating the Carbon Concentrating Mechanism (CCM). This biological process pumps CO2 into cells and concentrates it around an enzyme so CO2 can be synthesized into sugars for cellular growth. To operate the CCM, the cells also need to make a special structure in the chloroplasts called the pyrenoid that holds the pumped-in CO2. Without the pyrenoid, cells cannot grow at low CO2.
What the team found was the pyrenoid and CCM also allow the cells to grow at high oxygen, even if the CO2 levels are high.
"This was the first indication that the pyrenoid has a dual function!" said David Kramer, Hannah Distinguished Professor in Photo Synthesis and Bioenergetics in the Department of Biochemistry and Molecular Biology and a PRL faculty member. "It not only concentrates CO2 but protects against O2."
Signaling pyrenoid formation
The discovery of the signal for pyrenoid induction followed the researchers' observation that pyrenoids form not only under low CO2, but also hyperoxia. The researchers then asked: What chemical accumulates not only at low CO2, but at high oxygen that could trigger the pyrenoid?

The carbon concentrating mechanism (CCM). Credit: Kara Headley, MSU-DOE Plant Research Laboratory
Hydrogen peroxide, a common antiseptic that is also used in household products, is produced by plants and algae when photosynthesis is malfunctioning. Both low CO2 and high oxygen cause algal photosynthesis to make hydrogen peroxide. The cells likely detect this and make pyrenoids to fix the problem.
"It's been a big mystery as to how the algae know it's time to make the pyrenoid," Kramer said. "Now that we know a signal, we can potentially get the cells to make pyrenoids whenever we want. This could prepare them to work better during biofuel production."
Josh Temple, a Ph.D. student in the Kramer lab and paper co-author, added: "Despite an abundance of research on pyrenoids and the CCM, the mechanisms underlying their interaction still remain quite nebulous."
Applying findings for better crops
Researchers are constantly looking for ways to increase crop production. One idea is to introduce the algal CCM into land crops to improve the efficiency of photosynthesis. The issue is it is difficult to get the pyrenoid to form in plant cells.
"Now that we have an improved sense of the signal for an aspect of the CCM, we have a pathway to better understand the many genes involved in it," Neofotis said. "Such complete understanding is necessary if we ever want to transfer the algae CCM into land crops. Learning more about how the CCM is regulated also could help with efforts to engineer algae well suited for the conditions in biofuel facilities."
Knowing what induces the pyrenoid, a question debated for decades that remained unanswered until now, gives researchers a fuller understanding of not only algal cell biology, but also photosynthesis. As food and energy demand continues to increase, the Plant Research Laboratory remains committed to understanding how to optimize this important process.